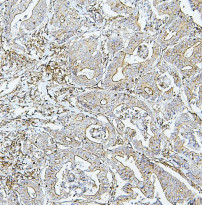

ARG43268
anti-IQGAP1 antibody
anti-IQGAP1 antibody for Flow cytometry,ICC/IF,IHC-Formalin-fixed paraffin-embedded sections,Western blot and Human,Rat
概述
| 产品描述 | Rabbit Polyclonal antibody recognizes GNAS2 / GNASs IQGAP1 |
|---|---|
| 反应物种 | Hu, Rat |
| 应用 | FACS, ICC/IF, IHC-P, WB |
| 宿主 | Rabbit |
| 克隆 | Polyclonal |
| 同位型 | IgG |
| 靶点名称 | IQGAP1 |
| 抗原物种 | Human |
| 抗原 | Recombinant protein corresponding to S2-H578 of Human IQGAP1. |
| 偶联标记 | Un-conjugated |
| 別名 | SAR1; Ras GTPase-activating-like protein IQGAP1; HUMORFA01; p195 |
应用说明
| 应用建议 |
|
||||||||||
|---|---|---|---|---|---|---|---|---|---|---|---|
| 应用说明 | * The dilutions indicate recommended starting dilutions and the optimal dilutions or concentrations should be determined by the scientist. | ||||||||||
| 实际分子量 | ~ 190 kDa |
属性
| 形式 | Liquid |
|---|---|
| 纯化 | Affinity purification with immunogen. |
| 缓冲液 | 0.2% Na2HPO4, 0.9% NaCl, 0.05% Sodium azide and 4% Trehalose. |
| 抗菌剂 | 0.05% Sodium azide |
| 稳定剂 | 4% Trehalose |
| 浓度 | 0.5 mg/ml |
| 存放说明 | For continuous use, store undiluted antibody at 2-8°C for up to a week. For long-term storage, aliquot and store at -20°C or below. Storage in frost free freezers is not recommended. Avoid repeated freeze/thaw cycles. Suggest spin the vial prior to opening. The antibody solution should be gently mixed before use. |
| 注意事项 | For laboratory research only, not for drug, diagnostic or other use. |
生物信息
| 数据库连接 |
Swiss-port # P46940 Human Ras GTPase-activating-like protein IQGAP1 |
|---|---|
| 基因名称 | IQGAP1 |
| 全名 | IQ motif containing GTPase activating protein 1 |
| 背景介绍 | This gene encodes a member of the IQGAP family. The protein contains four IQ domains, one calponin homology domain, one Ras-GAP domain and one WW domain. It interacts with components of the cytoskeleton, with cell adhesion molecules, and with several signaling molecules to regulate cell morphology and motility. Expression of the protein is upregulated by gene amplification in two gastric cancer cell lines. [provided by RefSeq, Jul 2008] |
| 生物功能 | Plays a crucial role in regulating the dynamics and assembly of the actin cytoskeleton. Binds to activated CDC42 but does not stimulate its GTPase activity. It associates with calmodulin. Could serve as an assembly scaffold for the organization of a multimolecular complex that would interface incoming signals to the reorganization of the actin cytoskeleton at the plasma membrane. May promote neurite outgrowth (PubMed:15695813). May play a possible role in cell cycle regulation by contributing to cell cycle progression after DNA replication arrest (PubMed:20883816). [UniProt] |
| 细胞定位 | Cell membrane. Nucleus. Cytoplasm. Note=Subcellular distribution is regulated by the cell cycle, nuclear levels increase at G1/S phase (PubMed:20883816). [UniProt] |
| 预测分子量 | 189 kDa |
| 翻译后修饰 | Phosphorylation of Ser-1443 by PKC/PRKCE prevents interaction between C1 and C2, allowing binding of nucleotide-free CDC42. Ser-1443 phosphorylation enhances the ability to promote neurite outgrowth. [UniProt] |
检测图片 (8) Click the Picture to Zoom In
-
ARG43268 anti-IQGAP1 antibody ICC/IF image
Immunofluorescence: A431 cells stained with ARG43268 anti-IQGAP1 antibody (green) at 2 µg/ml dilution, overnight at 4°C. DAPI (blue) for nuclear staining.
-
ARG43268 anti-IQGAP1 antibody IHC-P image
Immunohistochemistry: Paraffin-embedded Human lung cancer tissue. Antigen Retrieval: Heat mediation was performed in Citrate buffer (pH 6.0) for 20 min. The tissue section was blocked with 10% goat serum. The tissue section was then stained with ARG43268 anti-IQGAP1 antibody at 1 µg/ml dilution, overnight at 4°C.
-
ARG43268 anti-IQGAP1 antibody WB image
Western blot: 50 µg of sample under reducing conditions. U-87MG, HL-60, HeLa, U2OS and Caco-2 whole cell lysates stained with ARG43268 anti-IQGAP1 antibody at 0.5 µg/ml dilution, overnight at 4°C.
-
ARG43268 anti-IQGAP1 antibody FACS image
Flow Cytometry: A431 cells were blocked with 10% normal goat serum and then stained with ARG43268 anti-IQGAP1 antibody (blue) at 1 µg/10^6 cells for 30 min at 20°C, followed by incubation with DyLight®488 labelled secondary antibody. Isotype control antibody (green) was rabbit IgG (1 µg/10^6 cells) used under the same conditions. Unlabelled sample (red) was also used as a control.
-
ARG43268 anti-IQGAP1 antibody IHC-P image
Immunohistochemistry: Paraffin-embedded Human liver cancer tissue. Antigen Retrieval: Heat mediation was performed in Citrate buffer (pH 6.0) for 20 min. The tissue section was blocked with 10% goat serum. The tissue section was then stained with ARG43268 anti-IQGAP1 antibody at 1 µg/ml dilution, overnight at 4°C.
-
ARG43268 anti-IQGAP1 antibody IHC-P image
Immunohistochemistry: Paraffin-embedded Human rectal cancer tissue. Antigen Retrieval: Heat mediation was performed in Citrate buffer (pH 6.0) for 20 min. The tissue section was blocked with 10% goat serum. The tissue section was then stained with ARG43268 anti-IQGAP1 antibody at 1 µg/ml dilution, overnight at 4°C.
-
ARG43268 anti-IQGAP1 antibody IHC-P image
Immunohistochemistry: Paraffin-embedded Human rectal cancer tissue. Antigen Retrieval: Heat mediation was performed in Citrate buffer (pH 6.0) for 20 min. The tissue section was blocked with 10% goat serum. The tissue section was then stained with ARG43268 anti-IQGAP1 antibody at 1 µg/ml dilution, overnight at 4°C.
-
ARG43268 anti-IQGAP1 antibody IHC-P image
Immunohistochemistry: Paraffin-embedded Rat kidney tissue. Antigen Retrieval: Heat mediation was performed in Citrate buffer (pH 6.0) for 20 min. The tissue section was blocked with 10% goat serum. The tissue section was then stained with ARG43268 anti-IQGAP1 antibody at 1 µg/ml dilution, overnight at 4°C.